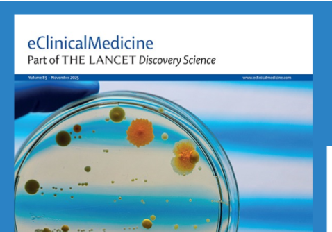
实时预警   动态监测！深睿医疗联合武大人民医院攻克难题

医疗健康最大的增量,在医院之外:AI 如何重构我们的生命掌控
谈及医疗健康,我们的第一印象往往是医院的诊疗场景、专业仪器与就诊流程。长期以来,现代医疗体系构建起 **“症状 - 诊断 - 治疗”** 的反应式闭环,本质是 “疾病发生后介入” 的补救模式。而科技演进正在颠覆这一
谈及医疗健康,我们的第一印象往往是医院的诊疗场景、专业仪器与就诊流程。长期以来,现代医疗体系构建起 **“症状 - 诊断 - 治疗”** 的反应式闭环,本质是 “疾病发生后介入” 的补救模式。而科技演进正在颠覆这一
摘要: 随着人工智能(AI)向通用人工智能(AGI)乃至超人工智能演进,人类面临着前所未有的“进化失配”风险。本文认为,AI治理的核心不在于单纯的技术限制,而在于维持人类物种的“进化稳态”。通过剥夺AI的元认知、建立
2月25日, 阜外华中心血管病医院“绿色导管室”投入临床使用,首台零射线精准射频消融手术同步顺利完成。 这标志着我院心律失常介入治疗正式实现从“射线依赖”到“绿色安全”的跨越,为华中地区心血管疾病患者带来了更精准、
·AI本身的能力与人类使用这种能力的效率之间存在巨大鸿沟。AI医生是否真的可靠?其性能能否仅靠增加算力来提升?2月10日发表在《自然-医学》上的一项新研究显示,对于普通人来说,答案是否定的。在该研究中,来自牛津大学等
数字医疗脑机接口,作为脑机接口技术在医疗健康领域的深度应用,正推动着从疾病诊疗到功能重建的全面变革。这项技术通过在大脑与外部设备间建立直接通信通路,实现对脑功能的监测、修复、增强或替代,已成为当今最具前景的医学前沿领
近日,首都医科大学附属北京安贞医院医学影像科徐磊教授团队与深睿医疗、北部战区总医院、山东省立医院、上海市第一人民医院、东部战区总医院等知名医疗机构一起合作攻关的重大研究成果,被放射学领域国际权威期刊《Radiolog
AI医疗已经成为近几年最受关注的赛道之一。从影像识别到辅助诊断,从智能随访到医疗大模型,AI正以前所未有的速度嵌入从三甲医院到基层中心的各个层级。然而,一个值得关注的现象正在显现:尽管 AI 医疗的部署范围持续扩大,
在科技飞速发展的今天,机器人正以前所未有的速度融入外科诊疗领域,为患者带来更精准、更安全的医疗体验,也为医生提供了更强大的技术支持。创新医疗服务的收费机制缺乏统一规范,在一定程度上影响了其临床推广与可持续发展。202
近日,深睿医疗携手武汉大学人民医院(湖北省人民医院)重症医学科詹丽英教授等团队在国际权威期刊 EClinicalMedicine(柳叶刀子刊IF:10,中科院1区TOP)联合发表重磅研究成果 -- 成功开发并验证了针
近日,深睿医疗与重庆市人民医院、重庆文理学院、浙江大学等多家单位联合攻关的 "复杂场景下多模态数据治理与AI识别模型的研发与应用" 项目,荣获重庆市科学技术奖!该项目通过构建高效、精准的人工智能混合识别模型,医工结合
人工智能正在重塑科学研究与创新的方式。科学家可以借助AI生成、汇总、整合并分析科学数据。AI模型能够从人类科学家可能忽略的数据中识别出模式,发现看似无关领域或现象之间的关联,甚至提出有待验证的新假设。AI 联合科学家
近日,由北京市科学技术协会主办,光明网承办,新村街道新联会与北京健嘉康复医院共同协办的科学文化沙龙在北京健嘉康复医院圆满举行。本次活动汇聚医学、科技、人文等多领域专家,开展深度对话与跨界交流,为推动科技人文融合发展贡

学习通是常用的学习工具,可以随时进行学习,找到你需要的资源,跨平台就能在线学习,了解学习的进度,但是很多小伙伴找不到入口在哪,下面就分享给大家。学习通网页版登录
点击阅读